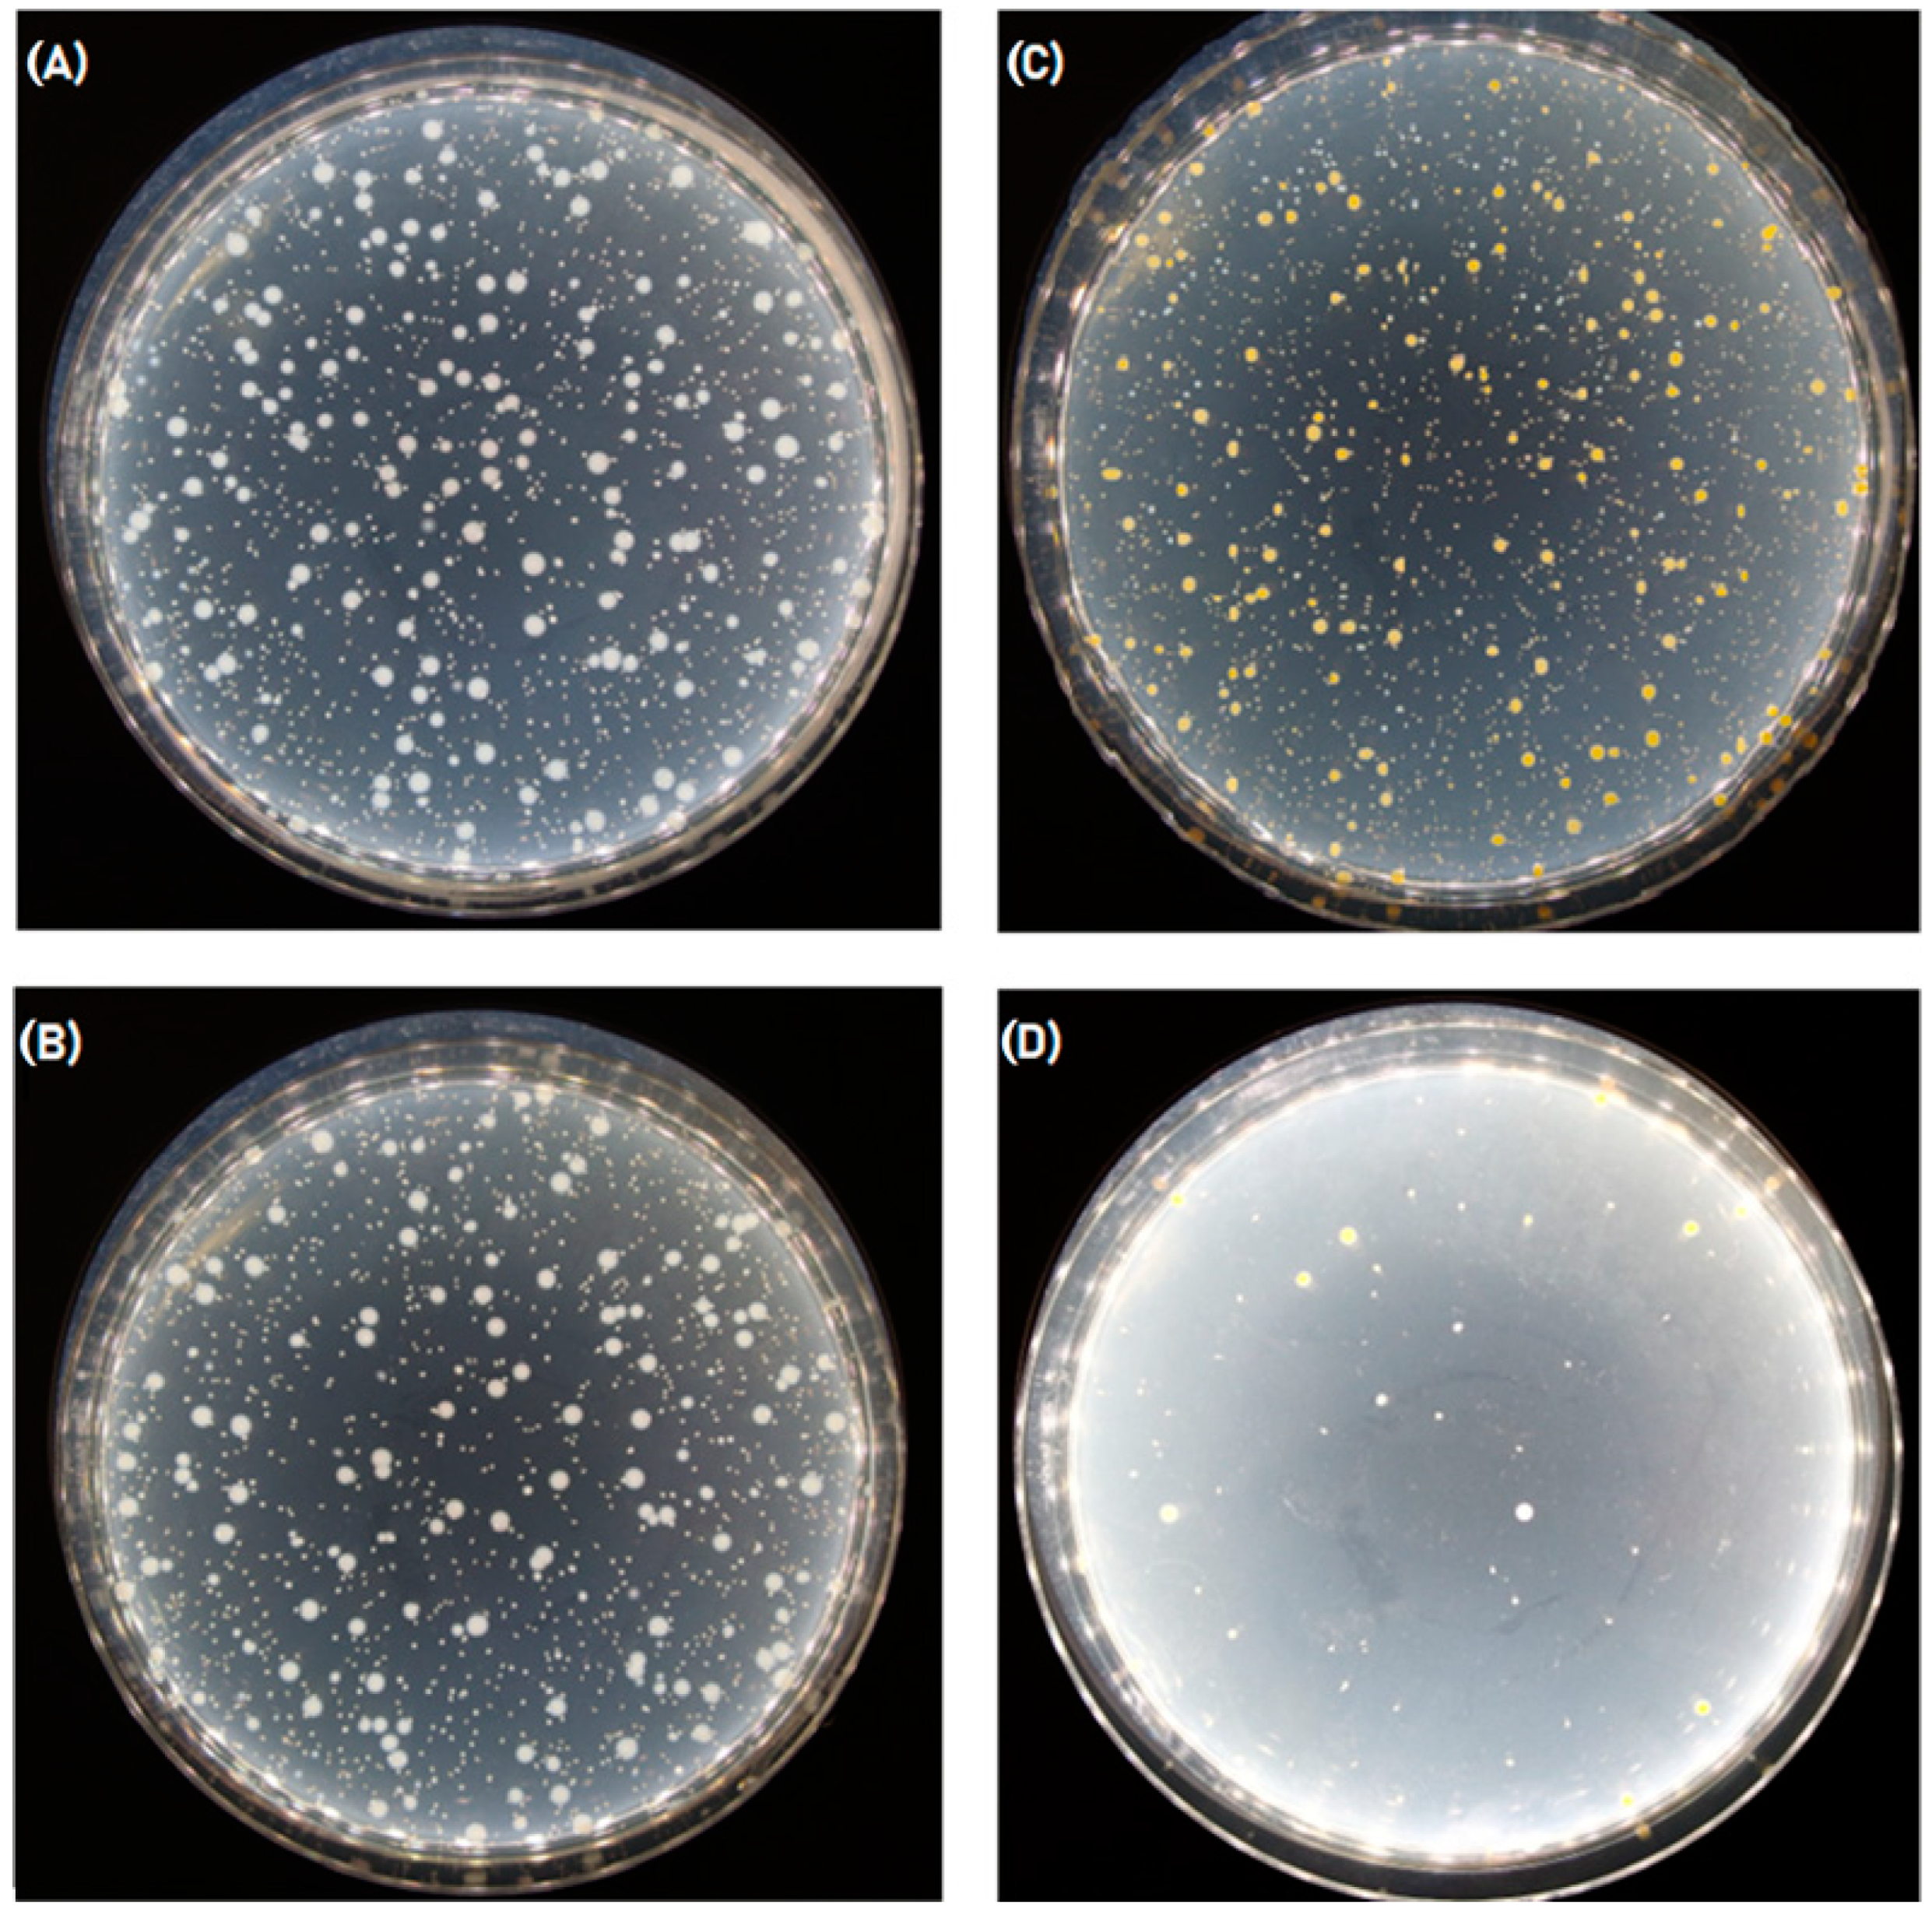
Polymers 16 00461 g007

Enhancing Chitosan Fibers: A Dual Approach with Tripolyphosphate and Ursolic Acid
Abstract
1. Introduction
2. Experimental Section
- 2-propanol (C3H8O) 99% Pure P.A. commercial product of Eurochem BGD from Zug, Switzerland.
- Ursolic acid (C30H48O3) ≥ 98% Pure P.A. commercial product of Pol-Aura from Gdańsk, Poland.
- Tripolyphosphate (TPP) (Na5P3O10), assay (unspecified): 90% min, Alfa Aesar from the Ward Hill, MA, USA.
- Chitosan powder commercial product of Sigma-Aldrich, from Darmstadt, Germany; molecular weight 60 kDa; degree of deacetylation (DDA) 96%.
- Acetic Acid (CH3COOH) 99% pure for analysis, commercial product of Poch from Gliwice, Poland.
- Sodium Hydroxide (NaOH) pure for analysis, commercial product of Poch from Gliwice, Poland.
2.1. Fiber Preparation
2.2. Fiber Impregnation Procedure for Antibacterial Properties’ Enhancement
2.3. Fiber Impregnation Procedure for Mechanical Properties’ Enhancement
2.4. Antibacterial Activity Test
- M—the number of bacteria per sample;
- C—sum of colonies in all plates from the calculated dilution;
- V—volume of inoculation applied to each plate in milliliters;
- n1—number of plates corresponding to the calculated dilution;
- d—the dilution rate corresponding to the calculated dilution;
- 20—amount of SCDLP in milliliters used to shake out the bacteria from the sample.
- lg Ct—common logarithm of the amount of bacteria on the control sample after 24 h incubation;
- lg C0—common logarithm of the amount of bacteria obtained from the control sample immediately after inoculation;
- lg Tt—common logarithm of the amount of bacteria obtained after 24 h incubation from the sample containing an antibacterial agent;
- lg T0—common logarithm of the amount of bacteria obtained from antibacterial testing samples immediately after inoculation.
2.5. Tensile Strength Test
3. Results
3.1. After-Fiber-Impregnation Procedure for Antibacterial Enhancement
3.1.1. FTIR Spectroscopy
3.1.2. Scanning Electron Microscope Images
3.1.3. UV-Vis Spectroscopy
3.1.4. Antibacterial Activity Test
3.2. After-Fiber-Impregnation Procedure for Mechanical Enhancement
3.2.1. FTIR Spectroscopy
3.2.2. Scanning Electron Microscope Images
3.2.3. Tensile Strength Test
4. Discussion and Conclusions
Author Contributions
Funding
Institutional Review Board Statement
Data Availability Statement
Acknowledgments
Conflicts of Interest
References
- Albanna, M.Z.; Bou-Akl, T.H.; Blowytsky, O.; Walters, H.L.; Matthew, H.W. Chitosan fibers with improved biological and mechanical properties for tissue engineering applications. J. Mech. Behav. Biomed. Mater. 2013, 20, 217–226. [Google Scholar] [CrossRef]
- Antaby, E.; Klinkhammer, K.; Sabantina, L. Electrospinning of Chitosan for Antibacterial Applications—Current Trends. Appl. Sci. 2021, 11, 11937. [Google Scholar] [CrossRef]
- Fan, M.; Hu, Q. Super Absorption Behavior of Chitosan by Freeze-Blasting in Different Alkaline Solvents. J. Renew. Mater. 2017, 6, 457–463. [Google Scholar] [CrossRef]
- Geng, L.; Lin, Y.; Chen, S.; Shi, S.; Cai, Y.; Li, L.; Peng, X. Superior strength and toughness of graphene/chitosan fibers reinforced by interfacial complexation. Compos. Sci. Technol. 2020, 194, 108174. [Google Scholar] [CrossRef]
- Sikorski, D.; Bauer, M.; Frączyk, J.; Draczyński, Z. Antibacterial and Antifungal Properties of Modified Chitosan Nonwovens. Polymers 2022, 14, 1690. [Google Scholar] [CrossRef] [PubMed]
- Vunain, E.; Mishra, A.K.; Mamba, B.B. Fundamentals of chitosan for biomedical applications. In Chitosan Based Biomaterials; Elsevier: Amsterdam, The Netherlands, 2017; Volume 1, pp. 3–30. [Google Scholar] [CrossRef]
- Becherán, L.; Bocourt, M.; Pérez, J.; Peniche, C. Chitosan in biomedicine. From gels to nanoparticles. In Advances in Chitin Science, Proceeding of the 6th Iberoamerican Chitin Symposium and 12th International Conference on Chitin and Chitosan, VI SIAQ/XII ICCC, Fortaleza, Brazil, 2–5 September 2012; Campana, S.P., Masumi, M.M., Flamingo, A., Eds.; São Carlos-IQSC: São Carlos, Brazil, 2014; pp. 217–224. [Google Scholar]
- Ahsan, S.M.; Thomas, M.; Reddy, K.K.; Sooraparaju, S.G.; Asthana, A.; Bhatnagar, I. Chitosan as biomaterial in drug delivery and tissue engineering. Int. J. Biol. Macromol. 2018, 110, 97–109. [Google Scholar] [CrossRef] [PubMed]
- Rinaudo, M. Chitin and chitosan: Properties and applications. Prog. Polym. Sci. 2006, 31, 603–632. [Google Scholar] [CrossRef]
- Kasaai, M.R. Various Methods for Determination of the Degree of N-Acetylation of Chitin and Chitosan: A Review. J. Agric. Food Chem. 2009, 57, 1667–1676. [Google Scholar] [CrossRef]
- Li, X.; Feng, Q.; Liu, X.; Dong, W.; Cui, F. Collagen-based implants reinforced by chitin fibres in a goat shank bone defect model. Biomaterials 2006, 27, 1917–1923. [Google Scholar] [CrossRef]
- Li, X.; Liu, X.; Dong, W.; Feng, Q.; Cui, F.; Uo, M.; Akasaka, T.; Watari, F. In vitro evaluation of porous poly(L-lactic acid) scaffold reinforced by chitin fibers. J. Biomed. Mater. Res. Part B Appl. Biomater. 2009, 90B, 503–509. [Google Scholar] [CrossRef]
- Wang, X.; Song, G.; Lou, T.; Peng, W. Fabrication of nano-fibrous PLLA scaffold reinforced with chitosan fibers. J. Biomater. Sci. Polym. Ed. 2009, 20, 1995–2002. [Google Scholar] [CrossRef]
- Albanna, M.Z.; Bou-Akl, T.H.; Walters, H.L.; Matthew, H.W. Improving the mechanical properties of chitosan-based heart valve scaffolds using chitosan fibers. J. Mech. Behav. Biomed. Mater. 2012, 5, 171–180. [Google Scholar] [CrossRef]
- Arora, B.; Tandon, R.; Attri, P.; Bhatia, R. Chemical Crosslinking: Role in Protein and Peptide Science. Curr. Protein Pept. Sci. 2017, 18, 77285. [Google Scholar] [CrossRef]
- Beppu, M.; Vieira, R.; Aimoli, C.; Santana, C. Crosslinking of chitosan membranes using glutaraldehyde: Effect on ion permeability and water absorption. J. Membr. Sci. 2007, 301, 126–130. [Google Scholar] [CrossRef]
- Yang, Y.; Chen, G.; Murray, P.; Zhang, H. Porous chitosan by crosslinking with tricarboxylic acid and tuneable release. SN Appl. Sci. 2020, 2, 435. [Google Scholar] [CrossRef]
- Muzzarelli, R.A.A.; El Mehtedi, M.; Bottegoni, C.; Aquili, A.; Gigante, A. Genipin-Crosslinked Chitosan Gels and Scaffolds for Tissue Engineering and Regeneration of Cartilage and Bone. Mar. Drugs 2015, 13, 7314–7338. [Google Scholar] [CrossRef] [PubMed]
- Pati, F.; Adhikari, B.; Dhara, S. Development of chitosan–tripolyphosphate fibers through pH dependent ionotropic gelation. Carbohydr. Res. 2011, 346, 2582–2588. [Google Scholar] [CrossRef] [PubMed]
- Jabeen, S.; Saeed, S.; Kausar, A.; Muhammad, B.; Gul, S.; Farooq, M. Influence of chitosan and epoxy cross-linking on physical properties of binary blends. Int. J. Polym. Anal. Charact. 2015, 21, 163–174. [Google Scholar] [CrossRef]
- Tabesh, E.; Salimijazi, H.; Kharaziha, M.; Hejazi, M. Antibacterial chitosan-copper nanocomposite coatings for biomedical applications. Mater. Today Proc. 2018, 5, 15806–15812. [Google Scholar] [CrossRef]
- Li, J.; Zhuang, S. Antibacterial activity of chitosan and its derivatives and their interaction mechanism with bacteria: Current state and perspectives. Eur. Polym. J. 2020, 138, 109984. [Google Scholar] [CrossRef]
- Wawro, D.; Stęplewski, W.; Dymel, M.; Sobczak, S.; Skrzetuska, E.; Puchalski, M.; Krucińska, I. Antibacterial Chitosan Fibres Containing Silver Nanoparticles. Fibres Text. East. Eur. 2012, 6, 24–31. [Google Scholar]
- Ardean, C.; Davidescu, C.M.; Nemeş, N.S.; Negrea, A.; Ciopec, M.; Duteanu, N.; Negrea, P.; Duda-Seiman, D.; Musta, V. Factors Influencing the Antibacterial Activity of Chitosan and Chitosan Modified by Functionalization. Int. J. Mol. Sci. 2021, 22, 7449. [Google Scholar] [CrossRef] [PubMed]
- Gadkari, R.R.; Ali, S.W.; Joshi, M.; Rajendran, S.; Das, A.; Alagirusamy, R. Leveraging antibacterial efficacy of silver loaded chitosan nanoparticles on layer-by-layer self-assembled coated cotton fabric. Int. J. Biol. Macromol. 2020, 162, 548–560. [Google Scholar] [CrossRef] [PubMed]
- Rinaldi, F.; Oliva, A.; Sabatino, M.; Imbriano, A.; Hanieh, P.N.; Garzoli, S.; Mastroianni, C.M.; De Angelis, M.; Miele, M.C.; Arnaut, M.; et al. Antimicrobial Essential Oil Formulation: Chitosan Coated Nanoemulsions for Nose to Brain Delivery. Pharmaceutics 2020, 12, 678. [Google Scholar] [CrossRef]
- Yuan, G.; Lv, H.; Zhang, Y.; Sun, H.; Chen, X. Combined Effect of Cinnamon Essential Oil and Pomegranate Peel Extract on Antioxidant, Antibacterial and Physical Properties of Chitosan Films. Food Sci. Technol. Res. 2016, 22, 291–296. [Google Scholar] [CrossRef]
- Jia, Z.; Shen, D.; Xu, W. Synthesis and antibacterial activities of quaternary ammonium salt of chitosan. Carbohydr. Res. 2001, 333, 1–6. [Google Scholar] [CrossRef]
- Ahmadi, H.; Jahanshahi, M.; Peyravi, M.; Darzi, G.N. A new antibacterial insight of herbal chitosan-based membranes using thyme and garlic medicinal plant extracts. J. Clean. Prod. 2021, 334, 130114. [Google Scholar] [CrossRef]
- Ghasemzadeh, F.; Najafpour, G.D.; Mohammadi, M. Antiinfective properties of ursolic acid-loaded chitosan nanoparticles against Staphylococcus aureus. Turk. J. Chem. 2021, 45, 1454–1462. [Google Scholar] [CrossRef]
- Wolska, K.; Grudniak, A.; Fiecek, B.; Kraczkiewicz-Dowjat, A.; Kurek, A. Antibacterial activity of oleanolic and ursolic acids and their derivatives. Cent. Eur. J. Biol. 2010, 5, 543–553. [Google Scholar] [CrossRef]
- Do Nascimento, P.G.G.; Lemos, T.L.G.; Bizerra, A.M.C.; Arriaga, M.C.; Ferreira, D.A.; Santiago, G.M.P.; Braz-Filho, R.; Costa, J.G.M. Antibacterial and Antioxidant Activities of Ursolic Acid and Derivatives. Molecules 2014, 19, 1317–1327. [Google Scholar] [CrossRef] [PubMed]
- Cunha, W.R.; de Matos, G.X.; Souza, M.G.M.; Tozatti, M.G.; Andrade e Silva, M.L.; Martins, C.H.; da Silva, R.; Da Silva Filho, A.A. Evaluation of the antibacterial activity of the methylene chloride extract of Miconia ligustroides, isolated triterpene acids, and ursolic acid derivatives. Pharm. Biol. 2010, 48, 166–169. [Google Scholar] [CrossRef] [PubMed]
- ISO 20743:2021; Textiles—Determination of Antibacterial Activity of Textile Products. International Organization for Standardization: Geneva, Switzerland, 2021.
- ISO 2062:2009; Textiles—Yarns from Packages—Determination of Single-End Breaking Force and Elongation at Break Using Constant Rate of Extension (CRE) Tester. International Organization for Standardization: Geneva, Switzerland, 2009.
- ISO 139:2005; Textiles—Standard Atmospheres for Conditioning and Testing. International Organization for Standardization: Geneva, Switzerland, 2005.
- Lin, H.-Y.; Yeh, C.-T. Controlled release of pentoxifylline from porous chitosan-pectin scaffolds. Drug Deliv. 2010, 17, 313–321. [Google Scholar] [CrossRef] [PubMed]
- Olszewska, M. Optimization and validation of an HPLC-UV method for analysis of corosolic, oleanolic, and ursolic acids in plant material: Application to Prunus serotina Ehrh. Acta Chromatogr. 2008, 20, 643–659. [Google Scholar] [CrossRef]
- Wei, M.-C.; Yang, Y.-C. Extraction characteristics and kinetic studies of oleanolic and ursolic acids from Hedyotis diffusa under ultrasound-assisted extraction conditions. Sep. Purif. Technol. 2014, 130, 182–192. [Google Scholar] [CrossRef]

| Linear Range (mg/mL) | y = ax + b (Linear Model) | Correlation Coefficient, R2 |
|---|---|---|
| 0.0220–0.270 | Abs. = 4.3595 mg/mL × Conc. + 0.0161 | 0.9925 |
| C7UA | Mass of UA mg/1 g of Chitosan Fibers |
|---|---|
| 2 h | 0.0039 |
| 4 h | 0.0038 |
| 6 h | 0.0040 |
| 8 h | 0.0038 |
| Sample ID | Incubation Time [h] | Number of Bacteria [CFU */pr] | Value of Antibacterial Activity “A” | Value of Growth |
|---|---|---|---|---|
| Laboratory control sample | 0 | 3.7 × 104 | -------- | 3.37 |
| 24 | 8.5 × 107 | |||
| 7% Chitosan reference | 0 | 3.1 × 104 | 0.04 | 3.40 |
| 24 | 7.8 × 107 | |||
| 7% Chitosan UA 2H | 0 | 2.8 × 104 | 0.25 | 3.24 |
| 24 | 4.8 × 107 |
| Sample ID | Incubation Time [h] | Number of Bacteria [CFU */pr] | Value of Antibacterial Activity “A” | Value of Growth |
|---|---|---|---|---|
| Laboratory control sample | 0 | 9.6 × 104 | --------- | 2.13 |
| 24 | 1.2 × 107 | |||
| 7% Chitosan reference | 0 | 9.6 × 104 | 0.32 | 2.45 |
| 24 | 2.7 × 107 | |||
| 7% Chitosan UA 2H | 0 | 6.7 × 104 | 2.93 | −0.68 |
| 24 | 1.4 × 104 |
| Efficacy of Antibacterial Properties | Value of Antibacterial Activity |
|---|---|
| low | A < 2 |
| significant | 2 ≤ A < 3 |
| strong | A ≥ 3 |
| Sample ID | Value of Antibacterial Activity “A” | |
|---|---|---|
| E. coli | S. aureus | |
| C7 reference | 0.32 Non-antibacterial | 0.04 Non-antibacterial |
| C7UA | 0.25 Non-antibacterial | 2.93 Significant |
| Specific Strength at Maximum Force (cN/tex) Average | Relative Elongation at Maximum Force (%) Average | |
|---|---|---|
| 14.25 | 3.94 | |
| Standard deviation | 0.56 | 0.74 |
| Coefficient of variation | 2.63 | 10.89 |
| Sample ID | Specific Strength at Maximum Force (cN/Tex) Average | Relative Elongation at Maximum Force (%) Average | Fiber’s Strength Improvement (%) | Fiber’s Elongation Improvement (%) |
|---|---|---|---|---|
| C7 reference | 12.39 | 3.59 | 0.00 | 0.00 |
| C7TPP 2 hours | 14.25 | 3.94 | 15.01 | 9.75 |
| C7TPP 4 hours | 14.20 | 3.89 | 14.60 | 8.35 |
| C7TPP 6 hours | 14.22 | 3.87 | 14.76 | 7.80 |
| C7TPP 8 hours | 14.17 | 3.90 | 14.36 | 8.63 |
Disclaimer/Publisher’s Note: The statements, opinions and data contained in all publications are solely those of the individual author(s) and contributor(s) and not of MDPI and/or the editor(s). MDPI and/or the editor(s) disclaim responsibility for any injury to people or property resulting from any ideas, methods, instructions or products referred to in the content. |
© 2024 by the authors. Licensee MDPI, Basel, Switzerland. This article is an open access article distributed under the terms and conditions of the Creative Commons Attribution (CC BY) license (https://creativecommons.org/licenses/by/4.0/).
Share and Cite
Hernández Vázquez, C.I.; Draczyński, Z.; Borkowski, D.; Kaźmierczak, D. Enhancing Chitosan Fibers: A Dual Approach with Tripolyphosphate and Ursolic Acid. Polymers 2024, 16, 461. https://doi.org/10.3390/polym16040461
Hernández Vázquez CI, Draczyński Z, Borkowski D, Kaźmierczak D. Enhancing Chitosan Fibers: A Dual Approach with Tripolyphosphate and Ursolic Acid. Polymers. 2024; 16(4):461. https://doi.org/10.3390/polym16040461
Chicago/Turabian StyleHernández Vázquez, César I., Zbigniew Draczyński, Dominik Borkowski, and Dorota Kaźmierczak. 2024. "Enhancing Chitosan Fibers: A Dual Approach with Tripolyphosphate and Ursolic Acid" Polymers 16, no. 4: 461. https://doi.org/10.3390/polym16040461
APA StyleHernández Vázquez, C. I., Draczyński, Z., Borkowski, D., & Kaźmierczak, D. (2024). Enhancing Chitosan Fibers: A Dual Approach with Tripolyphosphate and Ursolic Acid. Polymers, 16(4), 461. https://doi.org/10.3390/polym16040461

